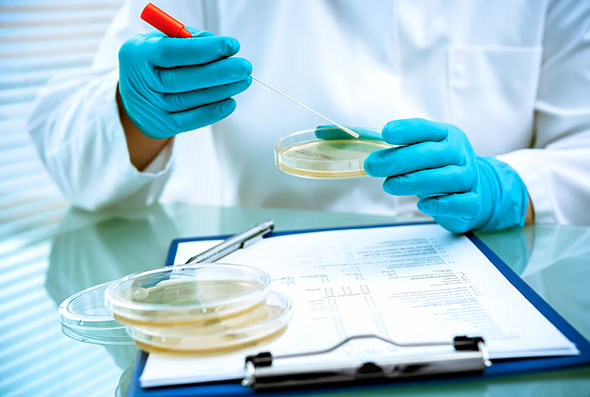
Scientist with petri dishes

Partner Art Garrett to Present at a myLawCLE Program on Insurance Coverage for Food Contamination and Recalls Incidents
Keller and Heckman Partner Art Garrett will present at the myLawCLE Program, Insurance Coverage for Food Contamination and Recalls Incidents, to be held virtually on December 11, 2025.
This CLE course will explore key insurance coverage issues related to food contamination and product recalls, focusing on CGL policies, first‑party property policies, and specialized contamination/recall coverage. Speakers will address third‑party claims (bodily injury, property damage, contaminated ingredients), first‑party losses (direct physical loss and exclusions), coverage triggers, reimbursable losses, conditions, exclusions, and the claims process. The program will also highlight D&O coverage considerations for recalls.
The session is designed for counsel advising food industry clients – from growers to processors, retailers, and restaurants – on navigating policy language, litigation risks, regulatory investigations, and crisis management in contamination and recall situations.
For more information, click here.